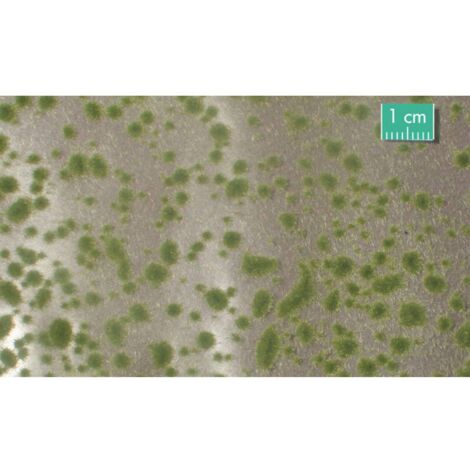
Mininatur 747-23 S Coussin en mousse début dautomne
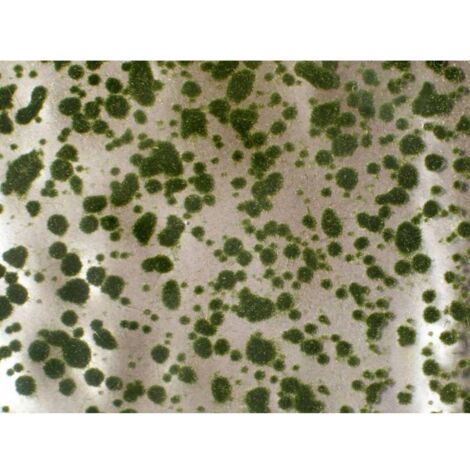
Mininatur 747-22 S Coussin en mousse été

Rocher et décoration pour bassin
130 produits trouvés
Filtrer par
0 filtre activé
Livraison gratuite
Prix
Notes
Marques
Vendeurs
Livraison
Éco-responsable
Origine France

Top ventes
Ubbink Décoration de jardin sous forme de faucon 40 cm
4 modèles pour ce produit
31€96
Livraison gratuite
Lanterne Flottante Lotus Natural Rose
3€95

Ubbink Statue de corbeau 27 cm Noir
5 modèles pour ce produit
24€06
Livraison gratuite
Mininatur 936-12 S Plantes grimpantes lierre
6€49

Fleurs de Lotus flottantes artificielles de 4 pouces étangs d'eau mousse feuille de Lotus faux lys pour plantes de décoration d'étang à la maison
8€7811€71
Livraison gratuite
Lotus artificiel Faux lotus flottant sur l'etang de l'aquarium Accessoires de decoration de surface de l'eau
9€9911€99
Livraison gratuite
Mininatur 973-22 Aiguilles dépicéa dété kit
18€9922€47

Lotus artificiel flottant faux lotus par le reservoir de poissons etang lac accessoires de decoration de surface de l'eau
4 modèles pour ce produit
14€9917€99
Livraison gratuite
ZOLUX Décoration naturelle racine maupani L - Pour aquarium
25€23
Livraison gratuite
Mininatur 792-22 S Arbuste lavande
6€49

Décor diffuseur air boudha sur ponton
7€49

7 pouces fleurs de Lotus flottantes artificielles étangs d'eau mousse feuille de Lotus faux lys pour piscine maison étang aquarium
15€8821€17
Livraison gratuite
Hippo Décor Statue Cracheuse d'Eau de Bassin Canalisé, polyrésine LO-Ron
26€4950€76

Racine naturelle Mangrove
24€05

Bac Pour Cascade, 61 X 71 cm, Décoration Pour Bassins De Jardin, Étangs
231€59
Livraison gratuite
Statue de jardin Gone Fishing Boy The Little Fisher Boy Décoration de jardin en plein air Figurine de pêcheur sculpture, finition en pierre LO-Ron
25€5949€10

Mininatur 936-22 S Plantes grimpantes lierre
6€49

Décor aquarium épave bateau - 30cm
37€99

Ubbink Cracheur de bassin en forme de grenouille 12 cm 1386008
37€8240€05
Livraison gratuite
Tronc d'arbre de décoration d'aquarium , résine cachant des grottes ornement de tronc d'arbre creux 15.5*10*8cm
18€5334€92

Mininatur 726-22 S Touffe de fleurs été
5€99

7 Pouces Artificielle Flottant Lotus Fleurs Étangs D'eau Mousse Feuille De Lotus Faux Nénuphar Flottant Piscine Maison Étang Fish Tank Décoration Plantes
4 modèles pour ce produit
13€9927€99
Livraison gratuite
Pagode Noire Décoration Bassin De Jardin et Jardin. Ambiance Zen Japon
87€59
Livraison gratuite
Diffuseur bouddha bonzaï 14,5 x 12 x 20 cm, décoration aquarium - zolux
32€99

Lot De 2 Décorations De Bassin De Jardin, Canard Màle Ou Colvert, Artificiel
43€67
Livraison gratuite
Mininatur 997-21 S Fleurs solidage du Canada, printemps
5€99

Mininatur 726-24 S Touffe de fleurs fin dautomne
5€99

Mininatur 998-21 S Fleurs printemps blanc
5€99

Mininatur 725-21 S Touffe de mauvaises herbes printemps
5€99

Mininatur 998-25 S Fleurs orange
5€99

Mininatur 726-23 S Touffe de fleurs début dautomne
5€99

Mininatur 725-23 S Touffe de mauvaises herbes début dautomne
5€99

Mininatur 726-21 S Touffe de fleurs printemps
5€99

Mininatur 727-24 S Touffe dherbe haute fin dautomne
5€99

Mininatur 727-23 S Touffe dherbe haute début dautomne
5€99

Mininatur 996-22 S Plante couvre-sol pervenche (foncé)
5€996€99

Mininatur 998-26 S Fleurs magenta
6€49

Mininatur 998-24 S Fleurs violet
6€49

Mininatur 998-23 S Fleurs rouge
6€49

Mininatur 998-22 S Fleurs jaune
6€49

Mininatur 997-22 S Fleurs été
6€49

Mininatur 766-21 S Plate-bande avec feuilles printemps
6€49

Mininatur 725-24 S Touffe de mauvaises herbes fin dautomne 310 mm
6€49

Mininatur 725-22 S Touffe de mauvaises herbes été
6€49

Mininatur 727-22 S Touffe dherbe haute été
6€49

Mininatur 727-21 S Touffe dherbe haute printemps
6€49

Mininatur 717-24 S Touffe dherbe rase fin dautomne
6€49

Mininatur 717-22 S Touffe dherbe rase été
6€49

Mininatur 999-22 S Fleurs lupin, été
6€49

Mininatur 766-22 S Plate-bande avec feuilles été
6€49

Mininatur 717-21 S Touffe dherbe rase printemps
6€49
Mininatur 747-23 S Coussin en mousse début dautomne
6€49
Mininatur 747-22 S Coussin en mousse été
6€49

Mininatur 993-22 S Plante couvre-sol pervenche (clair)
6€497€49

Résine Fish Tank non toxique Ornement brisé Barrel Cave Aménagement Décoration LO-Ron
8€2619€92

Silhouette 200-12 S Buisson été 55 mm
9€99

Aquarium Ornement en Résine, Décor de Grotte d'Aquarium, Ornement de Baril Cassé de Résine 9.5*7*5cm 2 Pièces Versailles rouge,noir
10€4620€26

Décoration pour aquarium, décorations pour aquarium, aquarium, décorations thématiques de résine d'aquarium, décoration pour aquarium(maison d'ananas)LO-Ron
10€8025€76

Aquarium Tronc d'arbre Décoration Décorations d'arbre d'aquarium Ont l'habitude de Décorer l'aquarium 15*5*7cm 2Pcs Versailles
11€0221€26

Aquarium Tronc d'arbre DéCoration, RéSine pour DéCoration Fish Tank, Apparence Naturelle 15*4*7cm Versailles
11€3121€80